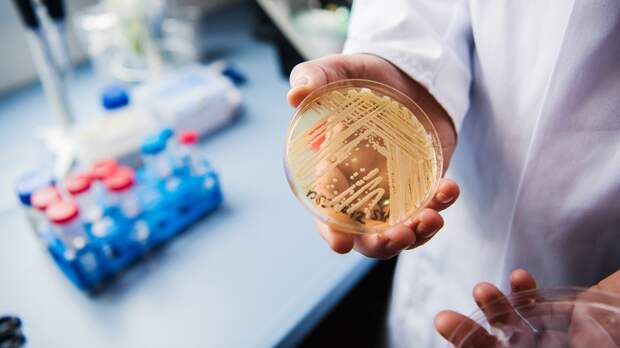

Доктор биологических наук Алексей Аграновский заявил, что традиционная селекция и отрасль генетически модифицированных продуктов должны развиваться параллельно.
Об этом Алексей Аграновский рассказал в беседе с ФАН.
«Я не противник генетически модифицированных продуктов.
В этой сфере есть свои группы интересов. Те доводы, которые приводят «ГМО-фобы», они не научные. Ни один серьёзный учёный не задействован в получении данных о том, что продукты с ГМО вызывают какие-то неприятные эффекты. Конечно, нужно проводить исследования в данной сфере, но делать это нужно с умом и без мракобесия», — отметил он.В мае сообщалось, что Министерство сельского хозяйства поддерживает упрощение допуска на российский рынок генно-модифицированной сои для кормов животных.
Свежие комментарии